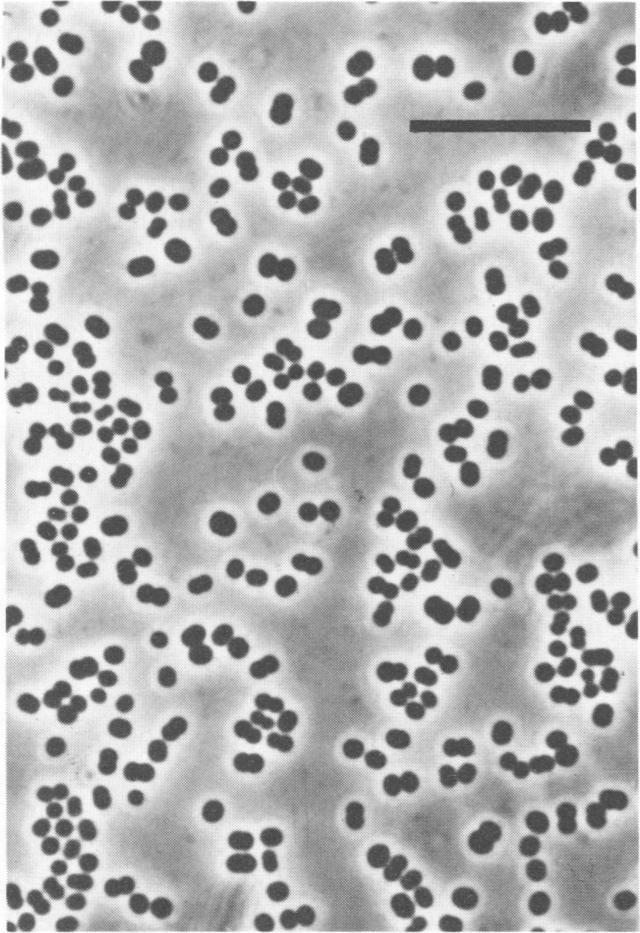
https://cdn.ncbi.nlm.nih.gov/pmc/blobs/86d8/202538/2bfa8327f7d3/aem00108-0153-b.jpg

Isolation and characterization of "Methanosphaera cuniculi" sp. nov.
作者信息
Biavati B, Vasta M, Ferry J G
机构信息
Istituto di Microbiologia Agraria, Universita di Bologna, Italy.
出版信息
Appl Environ Microbiol. 1988 Mar;54(3):768-71. doi: 10.1128/aem.54.3.768-771.1988.
Abstract
A nonmotile, gram-positive, spherical organism was isolated from the intestinal tracts of rabbits. Both hydrogen and methanol were required for growth. No methane was produced from hydrogen-carbon dioxide, formate, acetate, methylamines, ethanol, or isopropanol. The optimum pH was 6.8, and the optimum temperature was 35 to 40 degrees C. The DNA G+C content is 23 mol%. The pseudomurein cell wall contained serine. These characteristics and the immunological fingerprinting results are consistent with its placement in the genus Methanosphaera as a new species.
摘要